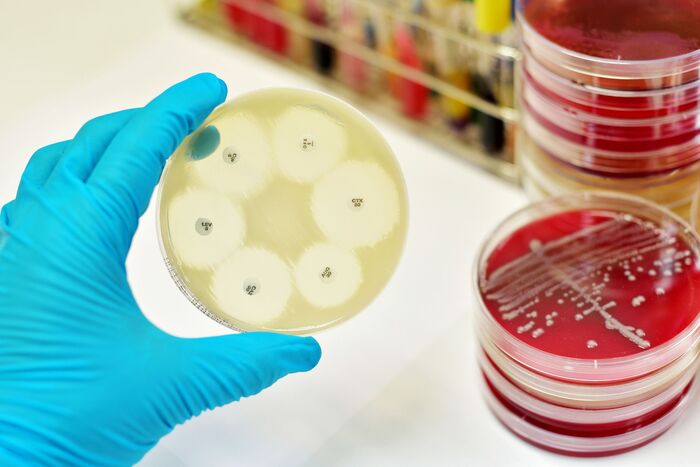

flipflopfloor
Жить нельзя подохнуть, или о микробах и устойчивости к антибиотикам
В качестве эксперимента - и ради давнего обещания - решила запилить пост)
[Для 12 людей, которые подписались и уже забыли, кто я - на связи нубовский учитель биологии, который обещал писать что-то на тему знаний, полезных в быту]
disclaimer 1: я не спец, советую относиться к моим почеркушкам, как к ликбезу для чайников. Ваши замечания и дополнения сама прочитаю с огромным интересом)
disclaimer 2: это мой первый длиннопост, если будут косяки - простите, в след.раз исправлюсь
В общем, хочу рассказать (тем, кто про это не слышал) о бактериях и том, почему мы вечно не можем юзать один и тот же антибиотик.
1. Типа-ликбез, который можно пропустить
На всякий случай напомню, что бактерии - одни из самых важных существ на Земле. В смысле, мы без них помрем, а они без нас прекрасно еще несколько миллиардов лет просуществуют. Сколько видов их есть на белом свете - не знает ни одна живая душа, но что точно известно - так это то, что бактерии умеют очень быстро эволюционировать.
У них для этого есть два лайфхака: 1. безумная плодовитость (например, кишечная палочка может делиться раз в двадцать минут) и 2. возможность внедрять в свою ДНК куски какой-то чужой. Это, конечно, может бактерию немножечко убить, но см.п.1. Кому-то да повезет.
Вставляют в свою ДНК что-то левое бактерии чаще всего одним из трех способов:
а) поглощая чужеродненькую ДНК из окружающей среды (это называется трансформацией). Теоретически бактерия может засосать что угодно, на практике все-таки большинство как-то выбирает (например, предпочитает ДНК близкородственных видов). Вобрав в себя такой "мусорный кусок", бактерия заменяет на него аналогичный участок ее ДНК и вуаля! новая версия себя самой готова.
Так можно заиметь разные скиллы. Например, если к безобидным стрептококкам бухнуть останки тех, которые вызывали пневмонию, то безобидные тоже станут опасными для человека.
Кот Леопольд в роли озверевшего стрептококка
Справедливости ради - как для того, чтобы жрать ночью из холодильника, так и для того, чтобы всасывать чужеродную ДНК, организмам нужно перейти в режим "голодное". Бактерии занимаются собственной трансформацией (если занимаются) только в определенный период жизни. Но, учитывая, как мало они живут, и сколько их на единицу поверхности, результат все равно велик и могуч.
б) второе, что приносит новые веяния в геном бактерий - это (тададам!) вирусы. Бактериальные вирусы порой напоминают воплощение ужастиков и в гробу видали подобную благотворительность, но... периодически во время сборки их частиц в зараженной клетке случается баг, и вместо вирусной ДНК в такую частицу запихивается кусок хозяйской.
Эта вирусная частица все равно будет искать другую бактерию, но вместо опасной программы впрыснет туда что-то (условно) годное, которое бактерия-счастливчик себе куда-нибудь запихнет. Такой расклад называется "трансдукция".
Возможно, у этой бактерии есть шанс на счастливое будущее
в) третий вариант, для Избранных, - страстные поцелуи. Они же конъюгация.
Чтобы уметь целоваться, бактерии нужно иметь определенные гены (которые она хранит на "переносной" ДНК, болтающейся внутри отдельно от основной). Такая клетка выпускает на поверхность специальные трубочки, цепляет ими другую товарку своего же вида, подтягивает к себе и, так сказать, запихивает в нее копии "избранных глав" из собственной ДНК. Довольно популярный способ, на самом деле.
минздрав предупреждает: беспорядочные конъюгации вредны для вашего здоровья
2. Про антибиотики и полирезистентность
Как нетрудно догадаться, если при приеме антибиотика какая-то бактерия приобретает к нему защиту (например, мутировала удачно, бактерии это тоже любят и практикуют) - она и сама размножится, и соседок вокруг научит. Иногда бактерии прямо распространяют через конъюгацию "сборники устойчивости", в которых содержится оптом до 10 генов, позволяющих не подохнуть от всякого разного.
Поэтому со временем конкретная форма антибиотика теряет свою эффективность. Сейчас этот процесс ускорился, и от момента появления лекарства до приобретения к нему устойчивости штамму бактерии нужно где-то 15-20 лет.
Если бактерию научилась бороться сразу с 3+ препаратами, она получает статус полирезистентной. Собственно, они чаще всего и появляются из-за неправильного применения антибиотиков (слишком частого, недостаточно долгого или с низкой дозировкой). Вообще такие бактерии не опаснее "обычных" и заражения вызывают не чаще, чем другие. Но если заразили - то вылечить человека намного сложнее, потому что часть лекарств просто ему не поможет.
из жизни диагностических лабораторий
Для здоровых людей с хорошим иммунитетом полирезистентные бактерии, как правило, безобидны, заразиться ими при контакте - риск минимальный, и можно их таскать с собой, не терпя при этом никакого урона. Опасными они становятся, если носителю делают операцию, потому что могут попасть в рану и устроить там сабантуй.
Но серьезная проблема в том, что такие носители могут неосознанно передать ПБ людям со слабым иммунитетом - и вот те-то могут заболеть.
В зоне риска, согласно найденной мной памятке, находятся люди, которые:
- последние полгода были в больнице/доме престарелых (т.к. чаще всего эти инфекции встречаются там, где много больных и ослабленных)
- последние полгода принимали антибиотики
- нуждаются в длительном уходе
- имеют открытые большие плохозаживающие раны или трубки (катетеры) в теле
- болеют чем-то, снижающим иммунитет (сахарный диабет, гепатит, ВИЧ) или принимают лекарства, которые его подавляют
Вообще медицина не стоит на месте, появляются новые препараты, новые протоколы лечения, врачи обмениваются опытом, и в целом человечество как-то с этим борется, но бактерии нам не уступают. Гонка вооружений, в которой надо бежать, чтобы оставаться на месте.
И это, говорят, нас еще грибы толком не разглядели.
а вот если разглядят, будет интересненько
Ну и таки шо рекомендуют делать в обычной жизни, особенно тем, кто живет с людьми из группы риска:
- мыть руки. Регулярно, тщательно, со вкусом. Лучшая защита - это просто не распространять)
- завести себе (если еще не) индивидуальные полотенца, мочалки, предметы гигиены. Если у вас одна зубная щетка на пятерых, советую подумать о переходе на размочаленные веточки дерева
- то из одежды и посуды, что можно мыть и стирать при 60С - стирать и мыть при 60С, хотя бы периодически. Большинство бактерий при этом дохнет.
- регулярно убираться. Париться на тему специальных дезинфецирующих средств для уборки имеет смысл тогда, когда кто-то дома страдает заразной болезнью или со слабым иммунитетом, а так просто достаточно жить в чистоте)
- не забивать болт на правила гигиены при визите в инфекционные больницы
- если предстоит операция - поговорить с врачом, не нужно ли заранее сдать анализ на полирезистентные бактерии
- а вообще проверяться не обязательно, и, если вы здоровы, то можно спокойно общаться с носителями полирезистентных бактерий. Но руки мыть все равно не забывайте)
И да, с антибиотиками надо обращаться осторожней.
Если кому интересно, что почитать, рекомендую эти ссылки (часть моего поста - перефразированная копипаста оттуда):
https://postnauka.ru/themes/antibiotiki
https://www.bundesaerztekammer.de/fileadmin/user_upload/down...
маленькая просьба: если вам понравилось, дайте знать :) а то времени куча уходит на написание, я хотела бы понять, интересно оно кому-то или не особо
О чем бы вы хотели, чтобы вам в свое время рассказали про человека на уроках биологии?
У меня есть чудесная возможность рассказывать ребятам 16-18 лет о биологии человека, не цепляясь за школьную программу. Составляя план, я задумалась над жизнью))
Классический курс анатомии (для непрофильных классов) хорош для ликбеза, но многое остается за бортом. Например, как именно работают вакцины, о чем стоило бы знать при посещении спортзала, основы правильного питания, биоритмы и гигиена сна, алкоголь, секс и половая физиология (о эти табу!), что делать, если обнаружили рак, и какие есть меры профилактики, и т.д.
Есть ли какие-то вещи, которые вы потом выясняли самостоятельно в более взрослом возрасте и думали, что было бы круто знать это заранее? Понятно, что не все это актуально в школе, но все-таки мне интересно)
Биология в быту1
Всем привет! Пишу на Пикабу в первый раз, так что сорри, если что не так.
Я работаю учителем в школе, и сегодня в классе, где я рассказывала цитологию, парень спросил: в чем смысл ему это знать? ("Все равно забуду", "можно погуглить" и т.п.).
Я не нашла аргументов, которые его бы убедили. А сама задумалась: есть же много бытовых примеров, где видно биологическое невежество. Уринотерапия, категорическое неприятие вакцин, женское обрезание, антибиотики от всего на свете и т.д.
Вдруг вы можете привести случаи, где незнание строения клетки сыграло с человеком злую шутку?
Ну, и вообще какие-то конкретные примеры и ситуации из жизни было бы интересно послушать. Не только про цитологию) Наберусь баек и буду потом школьников на раз-два притчами уделывать))